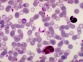

Да преборим рака... с бактерия
Бактерия, открита в почвата, дава доста добри резултати при лабораторните тестове срещу рак, съобщава ВВС.
» Прочети

Копенхаген без питейна вода
Части от датската столица Копенхаген останаха без чиста питейна вода, след като в обществената система за водоснабдяване бяха засечени високи равнища на бактерията Ешерихия коли.
» Прочети

Внимание! Атакува ни „суперсалмонела“
Какво по-подходящо от жега, мръсотия и лоша хигиена за една Салмонела? » Прочети

E.coli и в Чехия
Държавната селскостопанска и продоволствена инспекция на Чехия откри опасната бактерия E. » Прочети

Смъртоносната бактерия вече взема жертви в САЩ
Смъртоносната бактерия вече взема жертви и от другата страна на океана. » Прочети

Агенцията по храните започва проверка на зеленчуците
Проверка на вносните зеленчуци започват от Българската агенция за безопасност на храните. » Прочети

Бактерия на 250 млн. години
Най-старият микроорганизъм в света е бактерия, датираща отпреди 250 милиона години. » Прочети

Сифилисът е европейски, а не американски вирус
Британски археолози опровергаха битуващата от десетилетия теория, че сифилисът е пренесен от Америка в Европа от членове на експедицията на Христофор Колумб, съобщава БГНЕС.
» Прочети
Ново лечение срещу болестта на Чагас
Ново вещество, което да лекува успешно болестта на Чагас, са открили бразилски учени. » Прочети

Бактерия удължава живота
Бактерия, замразена преди хиляди години, може да помогне на хората да живеят до 140 години, твърдят учени, съобщава БГНЕС. » Прочети
